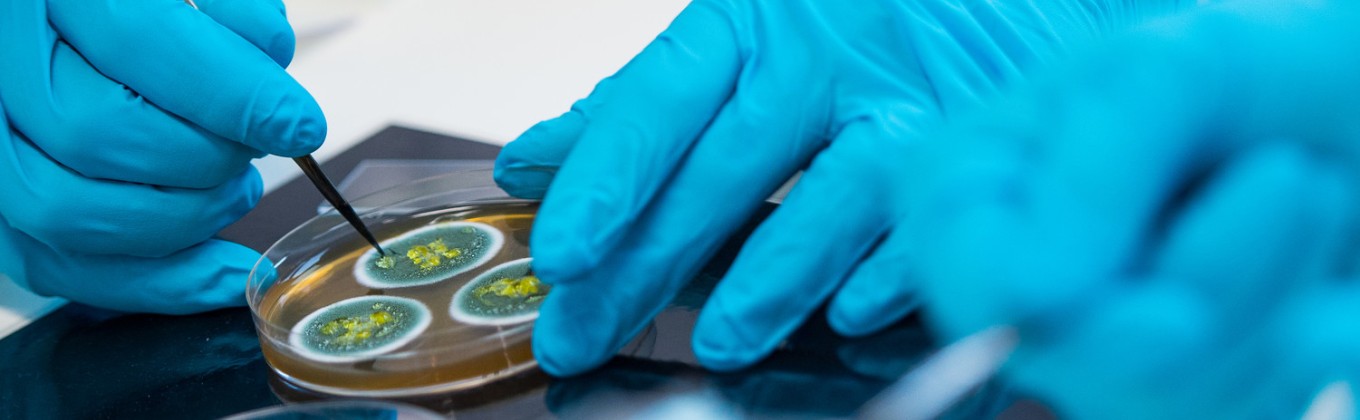
Gloved hands working with petri-dish

Business and industry
We forge alliances around basic research, contract research delivery or clinical translational research. If you are interested in working with us please contact the relevant research section lead directly for enquiries into establishing basic research collaborations.
Professional placement partnerships
Our Professional Training placements help to develop graduates who understand how they can apply their degree in the real world.
As part of the scheme a student would typically spend a year in a work (or research) setting related to their degree. During this year students are part of the work team, and they learn some of the skills that are needed in the workplace that are difficult to acquire in the classroom.
We have links with over 2,300 organisations of all sizes in the UK and overseas.
If you are interested in taking one of our highly talented students for a professional training year please contact our Employer Engagement team. Our Professional Training placements help to develop graduates who understand how they can apply their degree in the real world.
Recruit our graduates
We are proud of the calibre of students that graduate from our programmes each year. They are highly knowledgeable about their subject area and have the skills needed to transfer that knowledge into the workplace.
Many of our students graduate with a year of work experience gained through our Professional Training placements, and for those that don’t we try to embed the skills they will need in industry into their programme.
If you’d like to find out more about the ways you can get in touch with our students to help develop your workforce contact our Employer Engagement team.
Current vacancies
View the current job vacancies and PhD research opportunities available in the School of Biosciences.